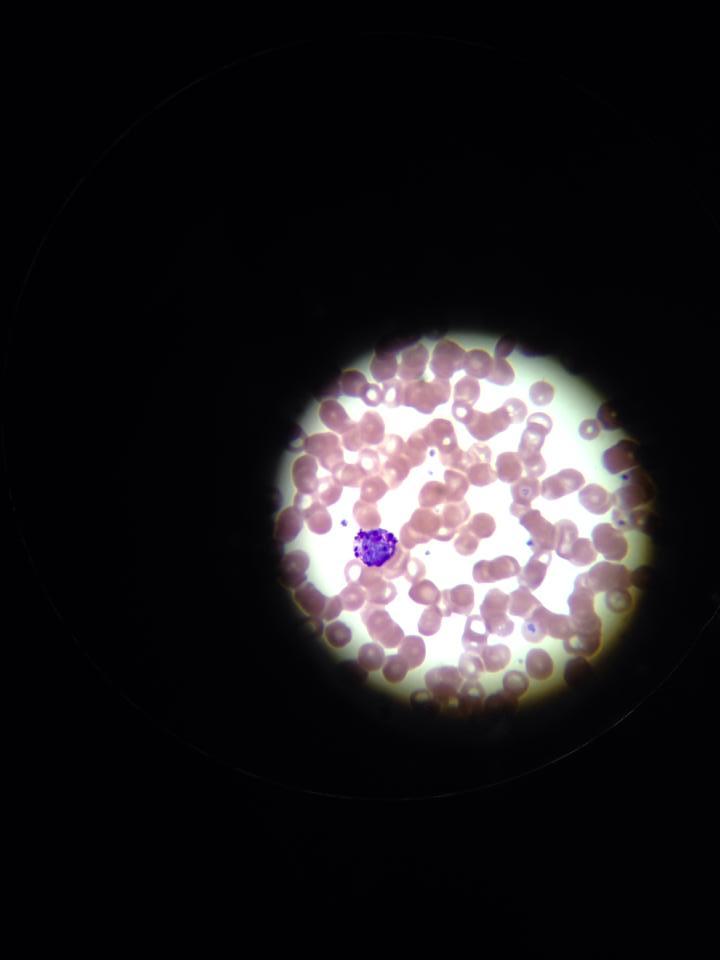
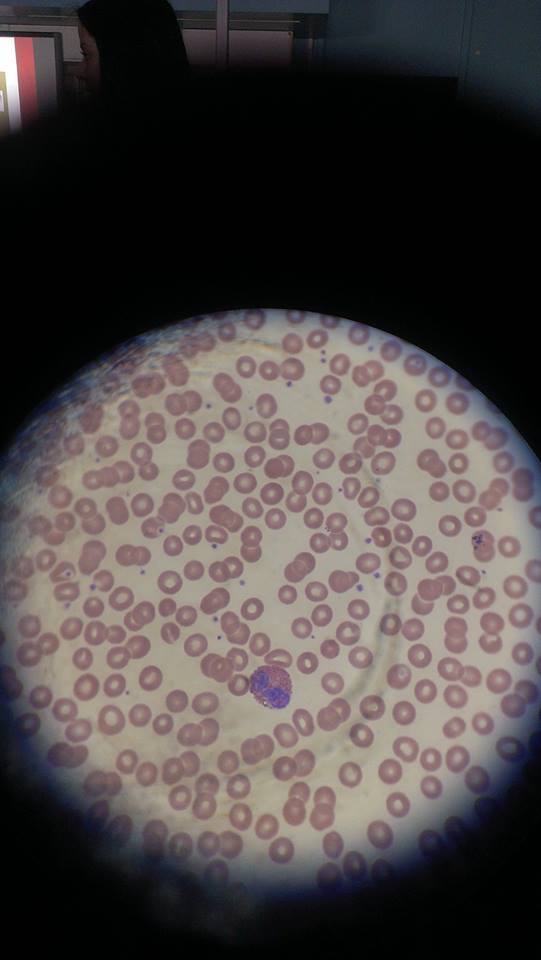
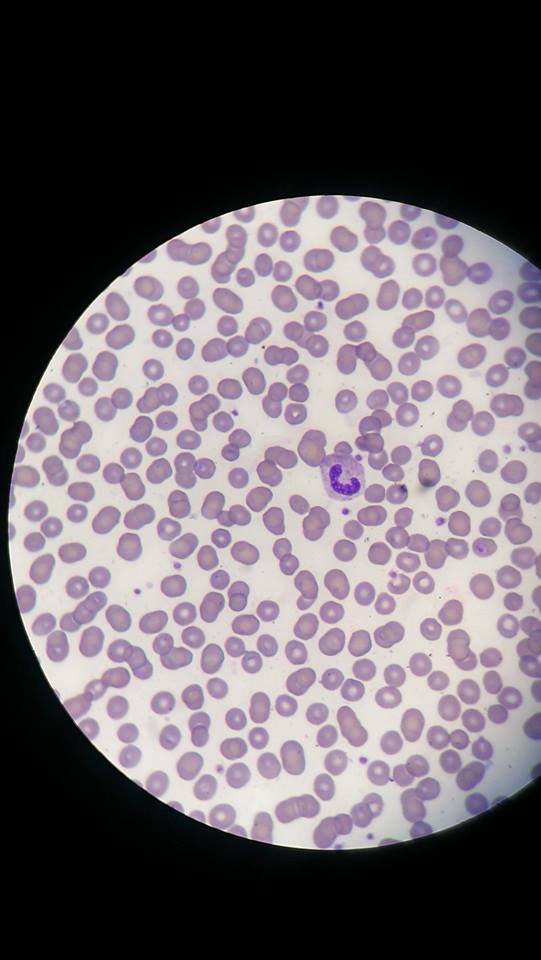
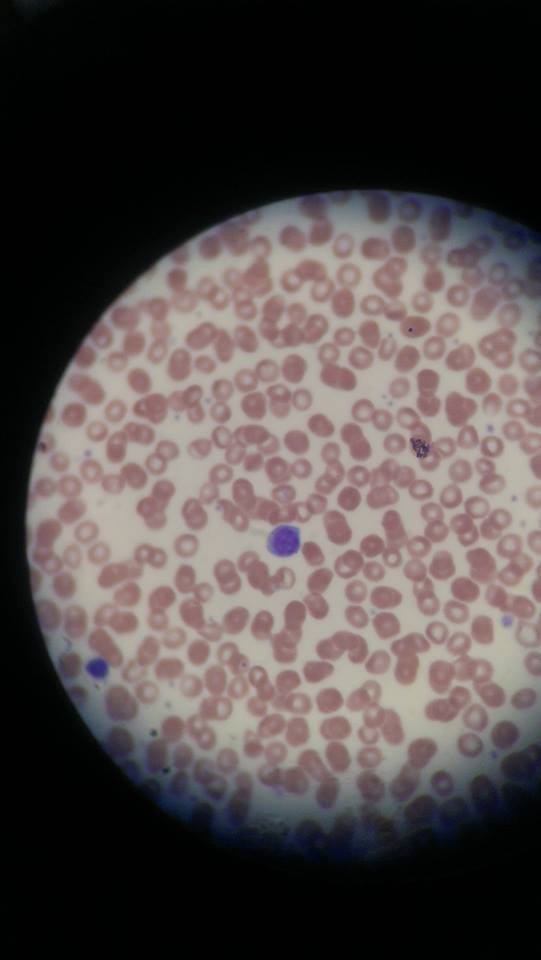
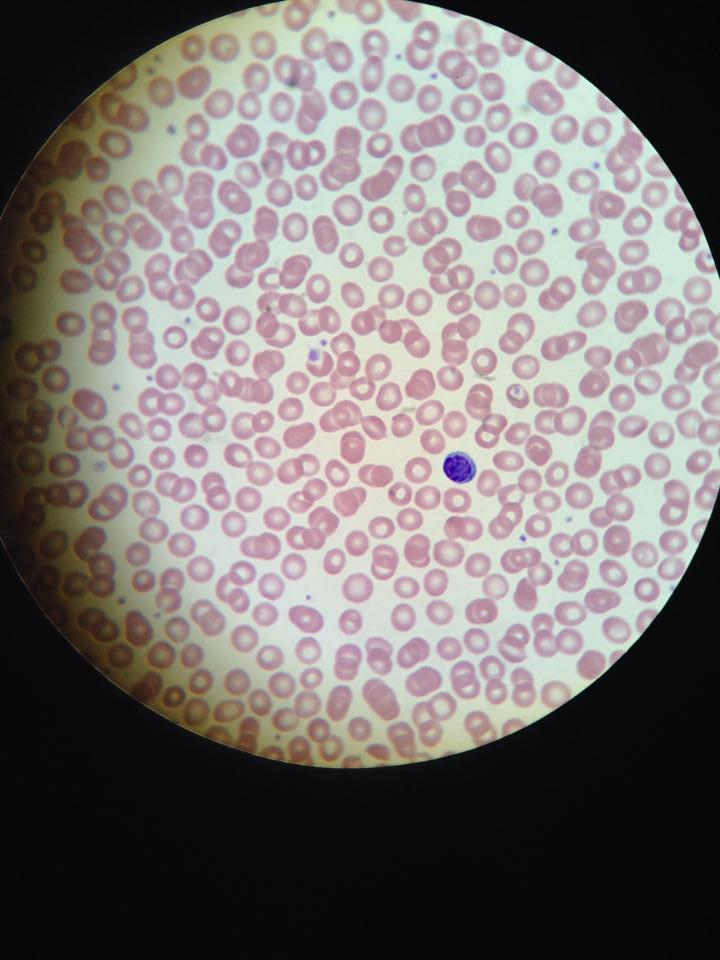
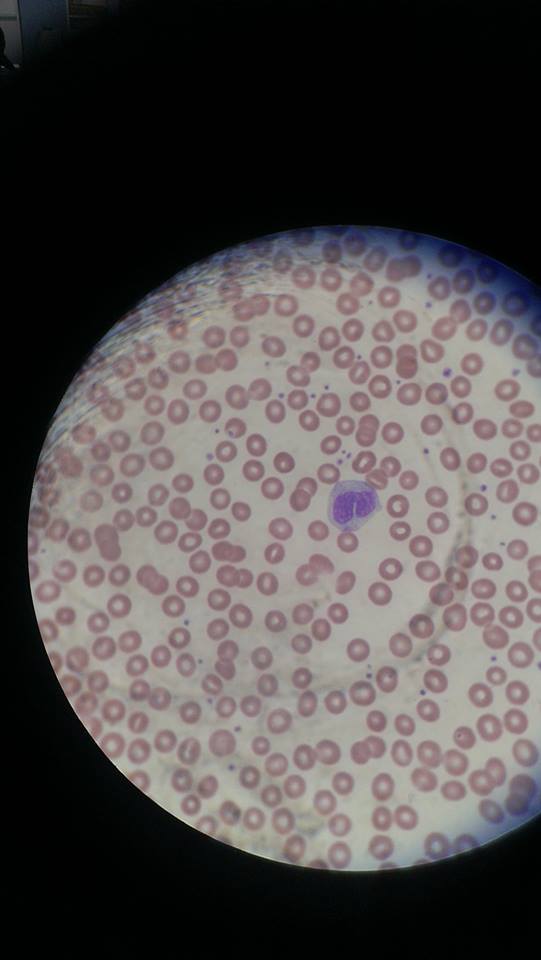
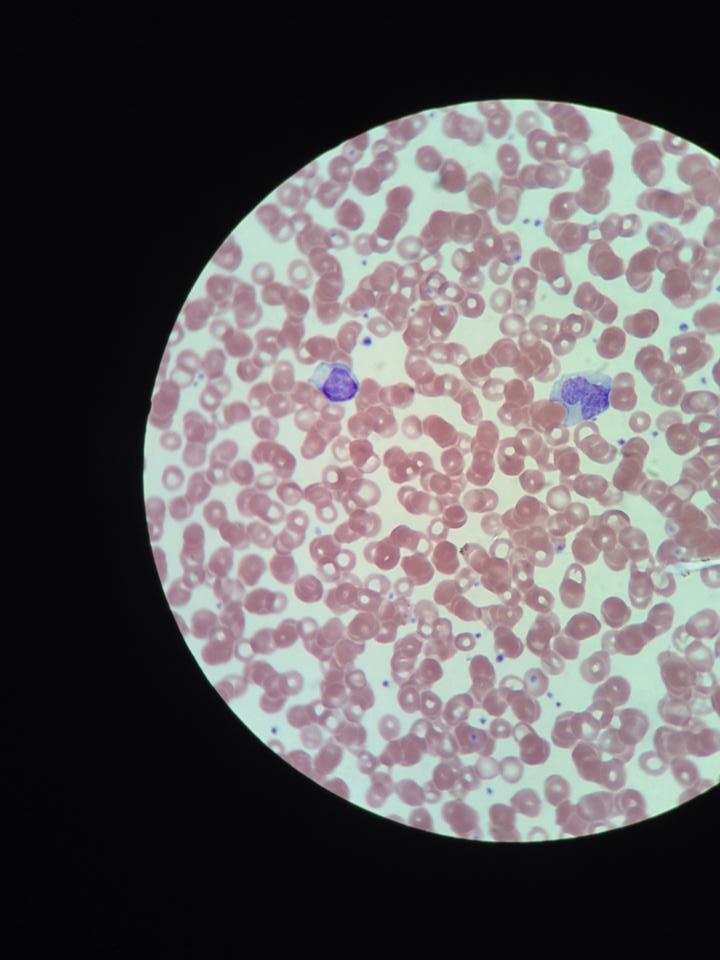
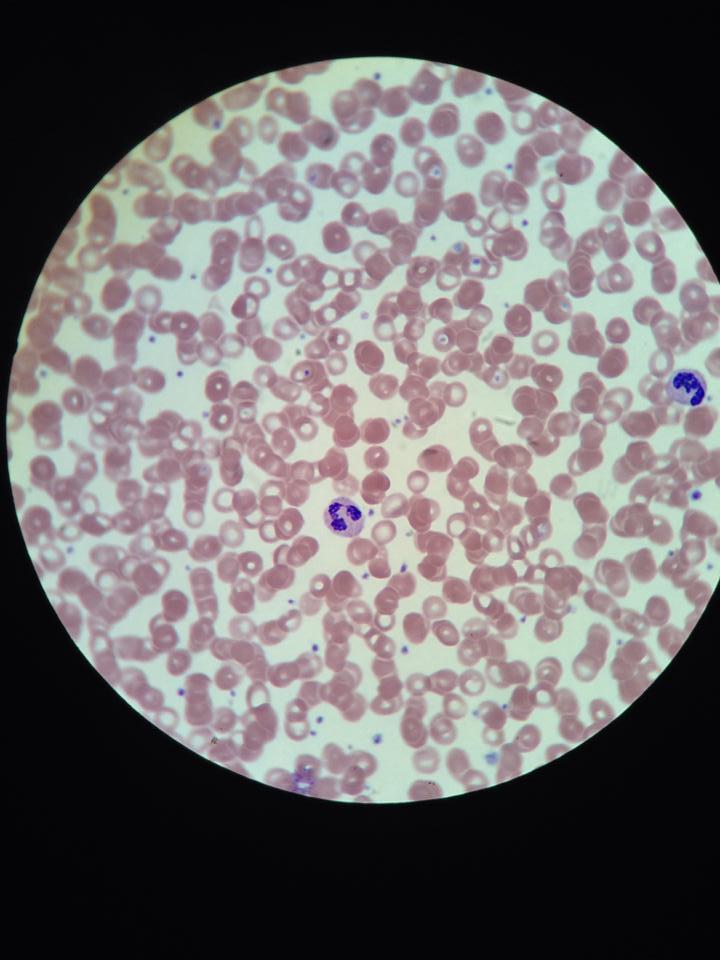

Adrenal Gland x40

Adrenal Gland x100

Artery

Basophil
Basophil
Eosinophil
Immature Neutrophil

Intercalated Disk (Heart)

Intercalated Disk
Lymphocyte
Lymphocyte

Mature Neutrophil
Monocyte
Monocyte
Neutrophil

Pancreas

Pancreas

Pituitary Gland

Thyroid and Parathyroid

Vein and Artery x100

Vein (left) and Artery (right)

Vein (left), and Artery (right)